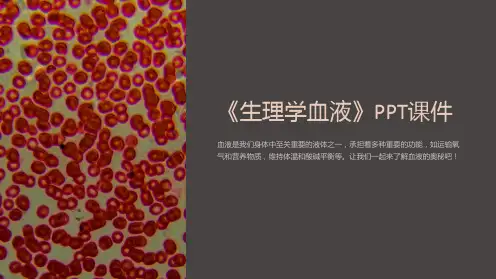

11
❖ (2)红细胞悬浮稳定性:指红细胞能相对稳定地 悬浮于血浆中不易下沉的特性。
❖ 红细胞沉降率(erythrocyte sedimentation rate, ESR )以红细胞在第一小时末下沉的距离来表示红 细胞的沉降速度。即第一小时末,玻璃管中析出的 血浆柱高度(mm)。
❖ 魏氏法 男性:0—15mm/h 女性:0—20mm/h ❖ 血沉快慢取决于— ❖ 红细胞是否容易相互叠连 ❖ 导致红细胞相互叠连的原因— ❖ 血浆成分改变
29
(二)、血液凝固的基本过程
内源激活途径 外源激活途径
↘
↙
凝血酶原激活物的形成
凝血酶原
凝血酶
纤维蛋白原 纤维蛋白
30
(三) 、抗凝系统
血浆中最重要的抗凝物质
1. 抗凝血酶III:能与凝血酶结合而
失活产生抗凝 2. 肝素:用于防治血栓性疾病
32
2、凝血过程的延缓和加速
影响因素 加快 接触面 粗糙
凝血因子。 2.种类:12种,即凝血因子FI~FXⅢ(无FVI )。此外,
还有前激肽释放酶、高分子激肽原。见PP64 表3-2 3.特点:
(1)本质:除因子Ⅳ为Ca2+,其余均为蛋白质。 26
(2)存在形式:因子Ⅱ、Ⅶ、Ⅸ、Ⅹ、 Ⅺ、Ⅻ及前激肽释放酶均为丝氨酸蛋白 酶,但正常情况下均以无活性的酶原形 式存在需激活后才有活性。
减慢或抗 凝
光滑
温度 化学物质
适当的升 温
维生素K
低温
草酸盐、
柠檬酸盐、
肝素
33
三、止血栓的溶解
纤维蛋白被分解液化的过程称为纤维蛋白溶解。
激活物
纤溶酶原
纤溶酶
纤维蛋白(原) 纤维蛋白降解产物